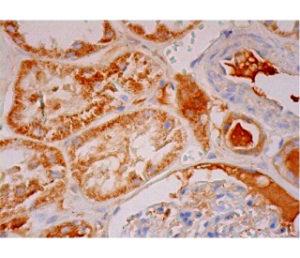

Market Research Explore recently Announces that, research report Global TSG6 Antibody Market 2018 analyzes the crucial factors of the TSG6 Antibody market based on present situations industry, market demands, business strategies Adopted By TSG6 Antibody market players and Their growth scenario. This report isolates the TSG6 Antibody market based on the key Vendors, Type and Applications.
Access Free Sample Copy of Research Report Here: https://www.marketresearchexplore.com/report/global-tsg6-antibody-market-analysis-2012-2017-and-forecast-2018-2023/80101#enquiry
Product Type Coverage:
Above 90%
Above 95%
Above 99%
Others
Company Coverage:
Thermo Fisher Scientific (US)
Aviva Systems Biology Corporation (US)
Abbexa Ltd (UK)
Boster Biological Technology (US)
Biobyt (UK)
The TSG6 Antibody report provides TSG6 Antibody policy, TSG6 Antibody economics, TSG6 Antibody sociology and TSG6 Antibody technology. Furthermore, the TSG6 Antibody Market are also covered at depth in this research document.
Initially, the TSG6 Antibody market players in driving business insights.
Acquire Full Copy of Research Report Here: https://www.marketresearchexplore.com/report/global-tsg6-antibody-market-analysis-2012-2017-and-forecast-2018-2023/80101
Key Highlights Of The TSG6 Antibody Market:
1. The fundamental details related to TSG6 Antibody industry like the product definition, product segmentation, price, variety of applications, demand and supply statistics are covered in this report.
2. The comprehensive study of TSG6 Antibody market based on development opportunities.
3. The study of emerging TSG6 Antibody market segments and the existing market segments wants to help readers in planning the business strategies.
Finally, the Global Report TSG6 Antibody Market 2018 TSG6 Antibody industry expansion game plan, the TSG6 Antibody industry knowledge supply, appendix, analysis findings and the conclusion.
